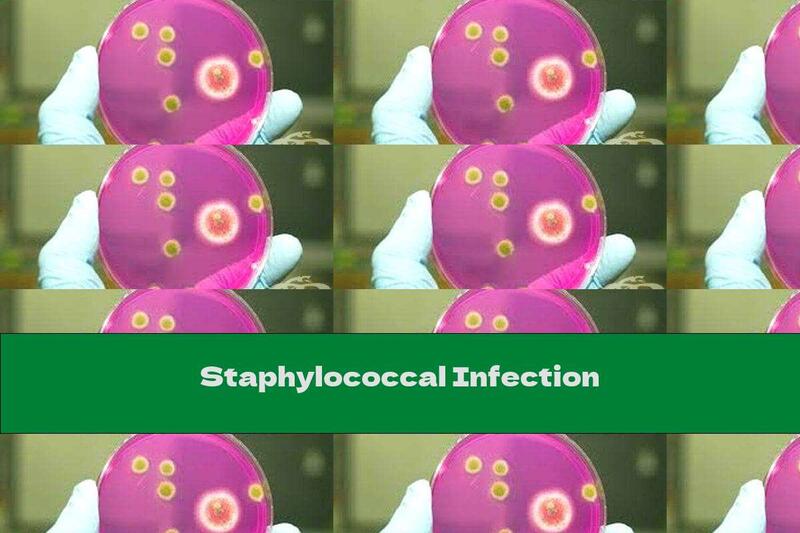
Staphylococcal Infection

Staphylococcal Infection
 Author: Maryam Ayres
Time for reading: ~1
minutes
Last Updated:
August 08, 2022
Author: Maryam Ayres
Time for reading: ~1
minutes
Last Updated:
August 08, 2022
CHAPTERS (Table Of Contents)
Staphylococcal infections are caused by certain types of staphylococcal bacteria. The clinical picture is different, characterized by purulent-inflammatory foci and intoxication of the body. Useful and harmful
Staphylococcal infections are caused by certain types of staphylococcal bacteria. The clinical picture is different, characterized by purulent-inflammatory foci and intoxication of the body.
Useful and harmful food products
There is no special diet to be followed in staphylococcal infection, but the patient must adhere to a proper diet for infectious diseases ( Healing diet № 13 ).
In acute forms of staphylococcal infection the body becomes intoxicated, there may be changes in the functions of individual organs, impaired energy metabolism of the body (consumes more energy), protein metabolism (there is increased protein breakdown), water-salt ( loss of minerals and fluid), reduces the amount of vitamins in the body.
The diet must provide enough of the necessary nutrients and energy for the body and its protective functions to function properly.
The menu should include products and dishes that are easy to digest. Feeding should be frequent, but small portions should be taken.
Recommended:- protein products (daily dose of 80 grams of protein, of which 65% are of animal origin) - minced / minced meat dishes, steamed, boiled fish, eggs (crumbs, steamed omelets, souffles), cottage cheese, various types of cream , oil, refined vegetable oil, olive oil;
- carbohydrate products (300 grams per day, of which 2/3 complex - porridge, potatoes, pasta and 1/3 easily digestible carbohydrates - jellies, mousses, honey, jam;
- products, sources of dietary fiber - fruits, vegetables, berries;
- abundant fluid intake - tea with milk, lemon, rosehip decoction, compotes, juices, skim milk drinks, table mineral water;
- products that increase appetite - sour milk drinks, low-fat fish and meat broths, sweet and sour fruit juices diluted with water, tomato juice;
- foods rich in vitamins A, B, C - pumpkin, carrots, sweet peppers, broccoli, spinach, parsley, pine nuts, walnuts, tuna, sea buckthorn;
During the recovery period the patient can adhere to a curative diet № 2 (with moderate stimulation of the gastrointestinal tract), and after recovery a curative diet № 15 (rational nutrition) is appropriate .
Dangerous and harmful food products in staphylococcal infection
Consumption of salt, strong coffee, tea, concentrated broths should be limited.
Exclude from the menu:- soybeans, peas, beans, lentils;
- cabbage;
- Rye bread;
- fried and breaded foods;
- fatty meats (lamb, pork, goose, duck);
- some species of fish, for example, sturgeon;
- smoked products, canned food;
- spices, in particular spicy (horseradish, pepper, mustard);
- bacon;
- alcoholic beverages .
Top Nutrition Articles Today
- . Rice Intolerance: Causes, Management, and Practical Tips
- . Red Beans And Rice
- . Harvard Nutrition Plate For Health And Weight Loss: Rules, E...
- . The Truth About Potato Chips: Health Effects and Alternative...
- . The Ultimate Guide to Black Lemons: Health Benefits, Culinar...
- . The Impact of All Restaurants on Nutrition: Fast Food vs. Fi...
- . Nutrition By Blood Type: Table Of Allowed And Prohibited Foo...
- . Water Pill Names
- . The Role of Calcium Lactate in Nutrition: Benefits, Sources,...
- . All You Need to Know About E 150d: Safety, Health Implicatio...